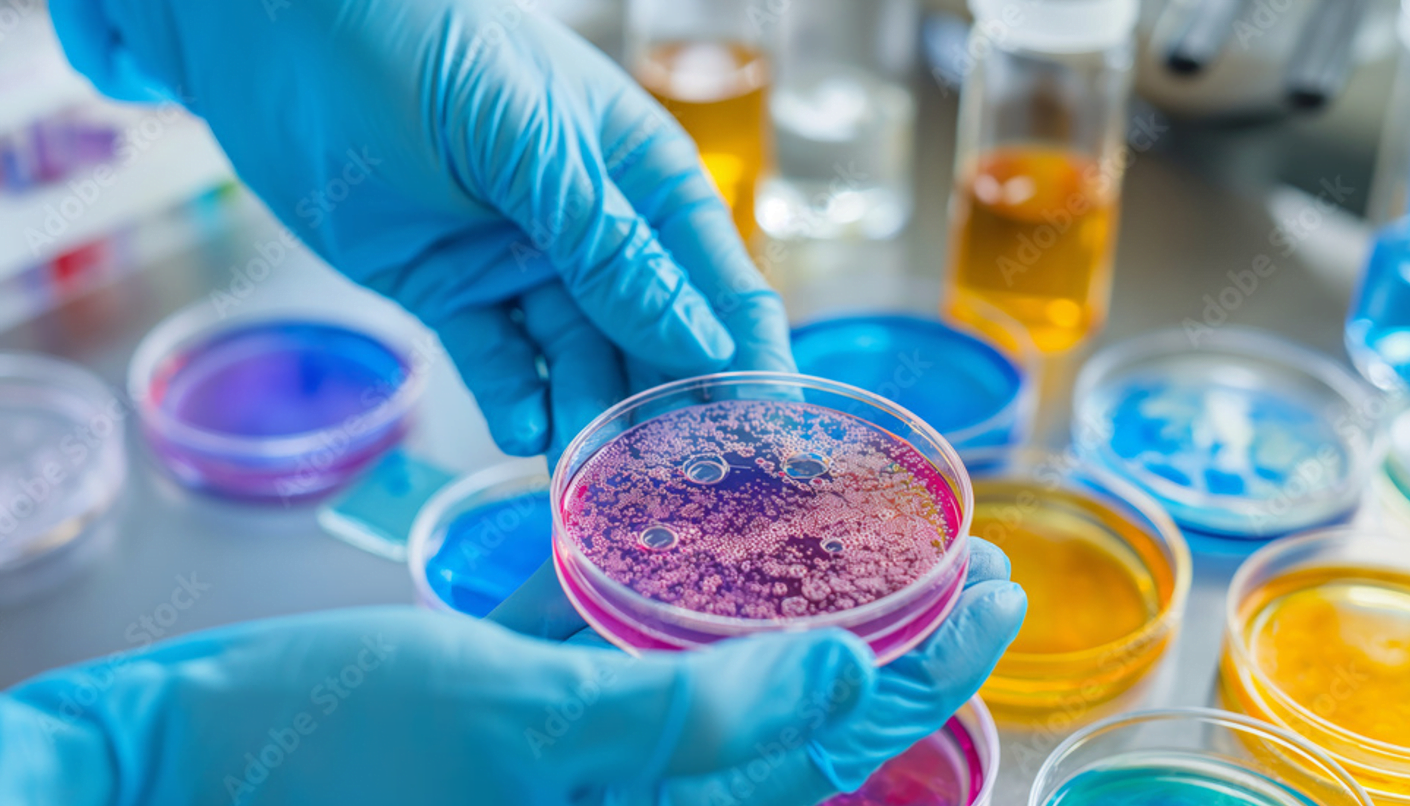

Bacterial, Fungal, and Endotoxin TestingBacterial, Fungal, and Endotoxin Testing
$99.00
Fill Out the Form Below to Get Started!
Contamination in drug and peptide samples poses significant risks to both patient safety and product efficacy. The presence of bacterial, fungal, or endotoxin contaminants can lead to severe complications in chemical research and analysis. These contaminants can compromise the stability and functionality of pharmaceutical products, undermining their therapeutic effectiveness. As a result, rigorous microbial contamination testing is imperative to ensure the highest standards of drug safety and quality.
The potential impacts of microbial contamination extend beyond immediate health risks. Contaminants can alter the chemical composition of drugs, leading to reduced potency or the generation of harmful byproducts. This can result in ineffective treatments or exacerbation of medical conditions. Furthermore, contamination incidents can lead to costly product recalls, legal liabilities, and damage to a company’s reputation.
Understanding and controlling microbial contamination is essential for the development of safe and effective pharmaceutical products. Implementing robust testing procedures are critical steps in safeguarding patient health and ensuring the integrity of drug and peptide samples.
Bacterial Contamination Testing Methods
Culture-based methods, such as the plate count method, have long been the cornerstone of bacterial contamination testing because it is the most effective and reliable technique. This method involves inoculating a sample, incubating it, and counting the number of colony-forming units (CFUs) to estimate the bacterial load. While highly reliable, the plate count method is time-consuming, typically requiring 24 to 72 hours for results, and may not detect viable but non-culturable bacteria.
Best practices for bacterial testing include maintaining aseptic conditions during sample handling, using validated and calibrated equipment, and adhering to established protocols. Regular training of personnel and stringent quality control measures are also essential to achieve accurate and reliable outcomes.
Fungal Contamination Testing Techniques
Identifying and quantifying fungal contamination in drug and peptide samples is crucial for ensuring product safety and efficacy. Traditional methods such as membrane filtration and direct inoculation have been widely used in the industry. Membrane filtration involves passing the sample through a filter that retains fungal spores, which are then cultured on selective media. This allows for the enumeration of viable fungi present in the sample. Direct inoculation, on the other hand, involves directly placing the sample onto a culture medium and observing fungal growth.
Endotoxin Testing Procedures and Standards
Endotoxin testing is a critical quality control measure for ensuring the safety of drug and peptide samples. One of the most widely adopted methods for endotoxin detection is the Limulus Amebocyte Lysate (LAL) test. The LAL test leverages the blood of horseshoe crabs, which clots in the presence of endotoxins. This assay is further divided into three main methodologies: gel-clot, turbidimetric, and chromogenic. Each method offers unique advantages in terms of sensitivity and quantification.
The gel-clot method is the most traditional form of LAL testing. It is a qualitative test that identifies the presence of endotoxins by the formation of a gel clot. It is highly sensitive and reliable, especially for routine screening. The turbidimetric method, on the other hand, measures the change in turbidity (cloudiness) of the sample, providing quantitative results. This method is advantageous for its rapid processing time and higher throughput capabilities. The chromogenic method measures the color change resulting from the reaction between endotoxins and the chromogenic substrate. It offers both qualitative and quantitative data, making it versatile for various analytical needs.
Certificate of Analysis (CoA)
After completing the bacterial, fungal, and endotoxin testing, we promptly provide a Lab Report with the results. This certificate includes detailed information about the results of the submitted samples, which is essential for your records and regulatory compliance. You can expect to receive the CoA within 2-5 business days of submitting your sample.
Why Choose Our Microbiology Services?
Our bacterial, fungal, and endotoxin testing services are the most affordable, accurate, and fastest in the market. Trust us to deliver reliable results in no time.
- Affordable: We guarantee you will not be able to find a better deal for the quality of work done on your samples.
- Accurate Testing: Our tests are highly precise and reliable, ensuring the best results for your research.
- Fast Results: We understand the importance of time in research, that’s why we deliver results in record time.
- Expert Analysis: Our team of experts will provide you with the best analysis and insights for your research.
FAQ
Do you have a sample report?
Yes, please see the top of this page for an example of the report that is produced.
I have 5 samples to submit, do you provide a discount?
At Forever Young Analytics, we give you the absolute best price available without having to jump through hoops of searching for coupons. We are confident that we are providing the best quality services at the most affordable price and are not able to bring our price lower for that reason.
Can I have any leftover sample mailed back to me?
The samples that are submitted to the lab are exposed to various chemical reagents and need to be unsealed to test the products. As a result it is not possible to mail samples back once they are submitted to the lab.
Do you have the instructions for mailing a sample to the lab
Yes, once your request is reviewed by our lab, an e-mail with the instructions for mailing a sample to the lab is e-mailed to you. It is also attached at the top of this page for your convenience.
Fill Out the Form Below to Get Started!
- No-Risk Money Back Guarantee!
- Secure Payments